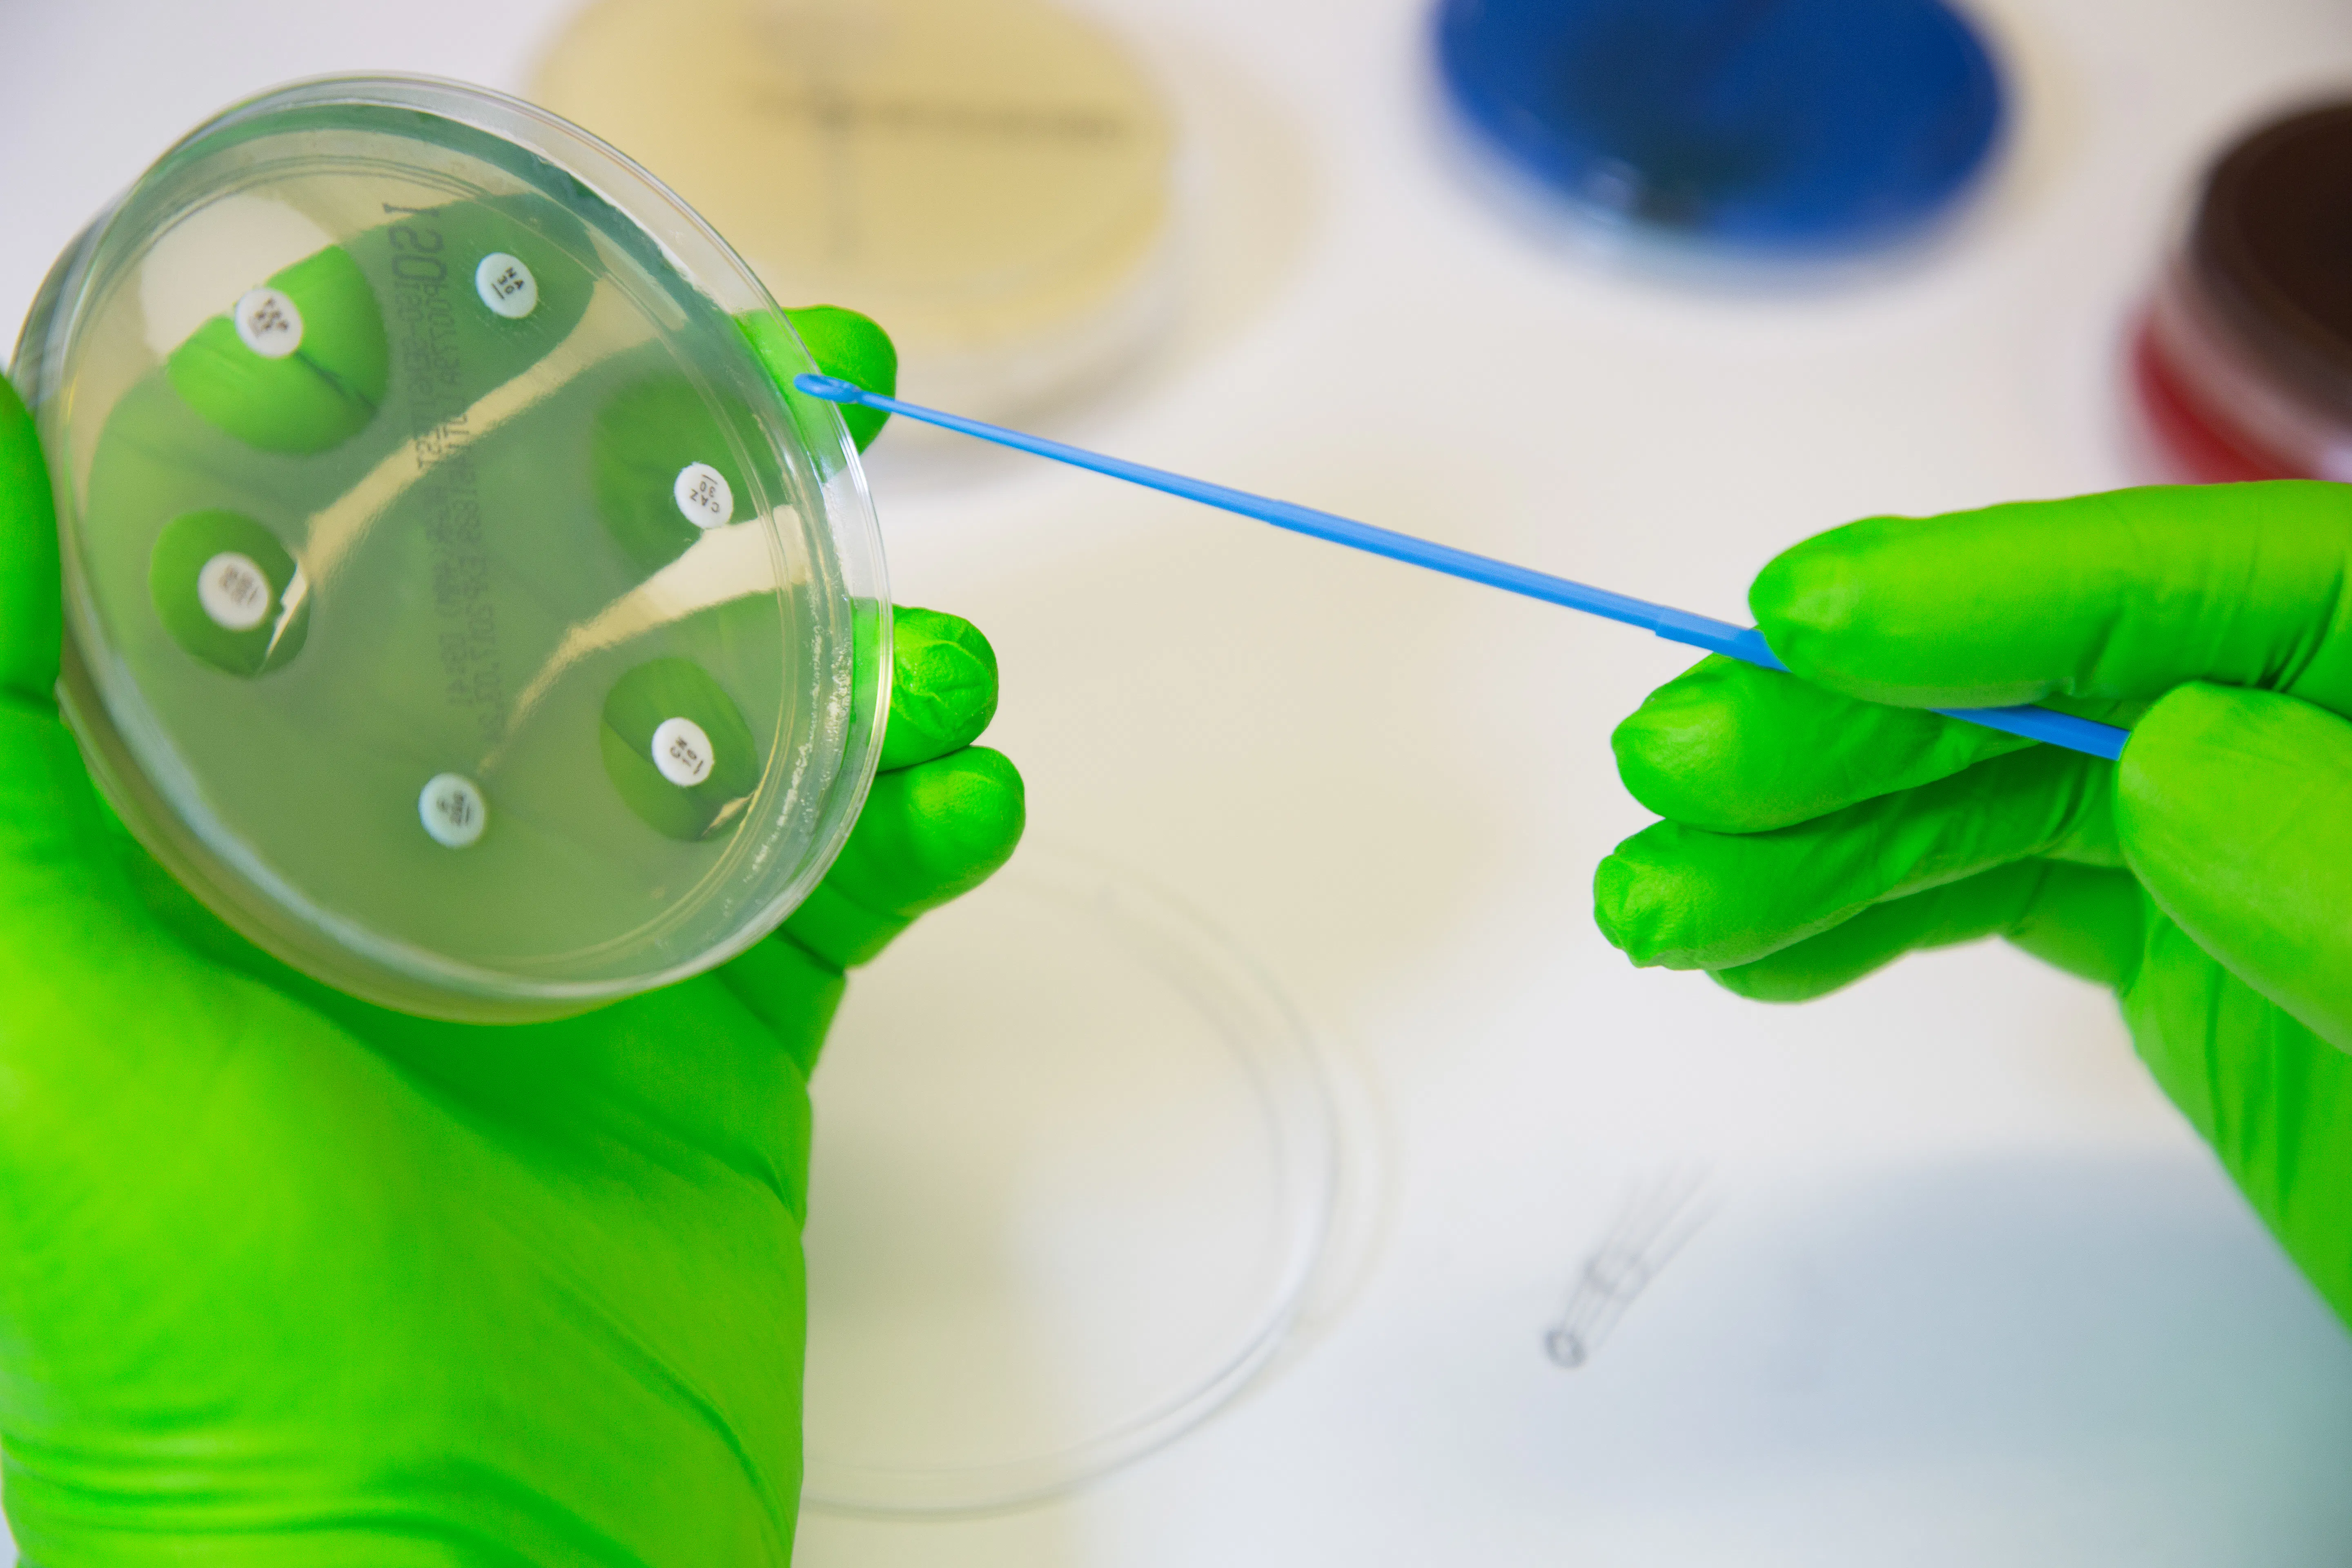

Overview
With Health Policy, Planning and Financing programme from London School of Hygiene and Tropical Medicine you’ll discover how to critically analyse health system issues, evaluate the effectiveness of policies, and devise appropriate health policy responses.
Co-designed and co-delivered with the London School of Economics & Political Science (the LSE), you’ll benefit from the expertise, resources and networks available at both institutions. And with staff who are world-leading researchers in their subjects, you’ll hear about the latest research and developments in the field from true global experts. By the end of the course, you could be making valuable contributions to local, national, or international health services and systems.
Learning Outcomes
By the end of this programme students will be able to:
- Critically understand a diverse range of international and national health policies, including current and emerging trends
- Gain knowledge of selected topics related to the study of health policy, planning and financing, such as epidemiology, health economics, and social sciences
- Develop skills in applying conceptual and theoretical knowledge using a multidisciplinary approach to formulate, design, implement, evaluate and appraise health policies and plans
- Know how to assess and communicate empirical evidence, including critically appraising debates relevant to issues of health policy
- Grow your research and presentation skills, including the ability to plan and carry out a literature search to evaluate research findings
Get more details
Visit programme websiteProgramme Structure
Modules include:
- Economic Evaluation
- Health Care Evaluation
- Sociological Approaches to Health
- Conflict & Health
- Design & Analysis of Epidemiological Studies
- Health Systems
- Economic Analysis for Health Policy
- Evaluation of Public Health Interventions
- Organisational Management
Check out the full curriculum
Visit programme websiteKey information
Duration
- Full-time
- 12 months
- Part-time
- 24 months
- Flexible
Start dates & application deadlines
- Starting
- Apply before , International
- Apply before , National
-
Language
Prepare for Your English Test
AI-powered IELTS feedback. Clear, actionable, and tailored to boost your writing & speaking score. No credit card or upfront payment required.
- Trusted by 300k learners
- 98 accuracy using real exam data
- 4.9/5 student rating
Credits
Delivered
Campus Location
- London, United Kingdom
Disciplines
Finance Health Administration Social Policy View 131 other Masters in Social Policy in United KingdomExplore more key information
Visit programme websiteWhat students do after studying
Academic requirements
English requirements
Prepare for Your English Test
AI-powered IELTS feedback. Clear, actionable, and tailored to boost your writing & speaking score. No credit card or upfront payment required.
- Trusted by 300k learners
- 98 accuracy using real exam data
- 4.9/5 student rating
Other requirements
General requirements
In order to be admitted to an LSHTM master's degree programme, an applicant must:
- hold either a first degree at Second Class Honours standard in a relevant discipline, or a degree in medicine recognised by the UK General Medical Council (GMC) for the purposes of practising medicine in the UK, or another degree of equivalent standard awarded by an overseas institution recognised by UK ENIC.
- hold a professional qualification appropriate to the programme of study to be followed obtained by written examinations and judged by LSHTM to be equivalent to a Second Class Honours degree or above.
- have relevant professional experience or training which is judged by LSHTM to be equivalent to a Second Class Honours degree or above.
Make sure you meet all requirements
Visit programme websiteTuition Fees
Visit programme websiteLiving costs
London
The living costs include the total expenses per month, covering accommodation, public transportation, utilities (electricity, internet), books and groceries.
Funding
Check for any work restrictions
Visit programme websiteIn order for us to give you accurate scholarship information, we ask that you please confirm a few details and create an account with us.
Scholarships Information
Below you will find Master's scholarship opportunities for Health Policy, Planning and Financing.
Available Scholarships
You are eligible to apply for these scholarships but a selection process will still be applied by the provider.
Read more about eligibility
Read more about eligibility
Read more about eligibility
Read more about eligibility
Read more about eligibility
Read more about eligibility
Read more about eligibility
Read more about eligibility
Read more about eligibility
Read more about eligibility
Read more about eligibility
Read more about eligibility
Read more about eligibility
Read more about eligibility
Read more about eligibility
Read more about eligibility
Read more about eligibility
Read more about eligibility
Read more about eligibility
Read more about eligibility
Read more about eligibility
Read more about eligibility
Read more about eligibility
Read more about eligibility
Read more about eligibility
Read more about eligibility
Read more about eligibility
Read more about eligibility
Read more about eligibility
Read more about eligibility
Read more about eligibility
Read more about eligibility
Read more about eligibility
Read more about eligibility
Read more about eligibility
Read more about eligibility
Read more about eligibility
Read more about eligibility
Read more about eligibility
Read more about eligibility
Read more about eligibility
Read more about eligibility
Read more about eligibility
Read more about eligibility
Read more about eligibility
Read more about eligibility
Read more about eligibility
Read more about eligibility
Read more about eligibility
Read more about eligibility
Read more about eligibility
Read more about eligibility
Read more about eligibility
Read more about eligibility
Read more about eligibility
Read more about eligibility